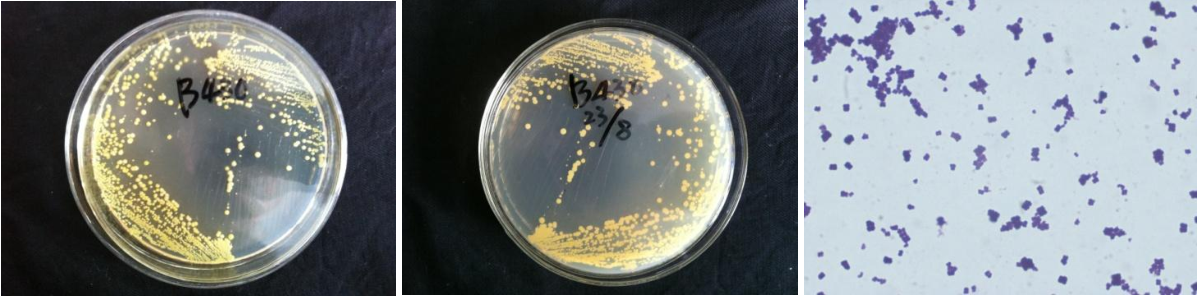

Loading...
| StrainNO | B430 |
| Classification | Micrococcus |
| 16s rDNA sequence | ACGTGAGTAACCTGCCCTTAACTCTGGGATAAGCCTGGGAAACTGGGTCTAATACCGGATAGGAGCGCCTACCGCATGGTGGGTGTT GGAAAGATTTATCGGTTTTGGATGGACTCGCGGCCTATCAGCTTGTTGGTGAGGTAATGGCTCACCAAGGCGACGACGGGTAGCCGG CCTGAGAGGGTGACCGGCCACACTGGGACTGAGACACGGCCCAGACTCCTACGGGAGGCAGCAGTGGGGAATATTGCACAATGGGCG CAAGCCTGATGCAGCGACGCCGCGTGAGGGATGACGGCCTTCGGGTTGTAAACCTCTTTCAGTAGGGAAGAAGCGAAAGTGACGGTA TCTGCAGAAGAAGCACCGGCTAACTACGTGCCAGCAGCCGCGGTAATACGTAGGGTGCGAGCGTTATCCGGAATTATTGGGCGTAAA GAGCTCGTAGGCGGTTTGTCACGTCTGTCGTGAAAGTCCGGGGCTTAACCCCGGATCTGCGGTGGGTACGGGCAGACTAGAGTGCAG TAGGGGAGACTGGAATTCCTGGTGTAGCGGTGGAATGCGCAGATATCAGGAGGAACACCGATGGCGAAGGCAGGTCTCTGGGCTGTA ACTGACGCTGAGGAGCGAAAGCATGGGGAGCGAACAGGATTAGATACCCTGGTAGTCCATGCCGTAAACGTTGGGCACTAGGTGTGG GGACCATTCCACGGTTTCCGCGCCGCAGCTAACGCATTAAGTGCCCCGCCTGGGGAGTACGGCCGCAAGGCTAAAACTCAAAGGAAT TGACGGGGGCCCGCACAAGCGGCGGAGCATGCGGATTAATTCGATGCAACGCGAAGAACCTTACCAAGGCTTGACATGTTCTCGATC GCCGTAGAGATACGGTTTCCCCTTTGGGGCGGGTTCACAGGTGGTGCATGGTTGTCGTCAGCTCGTGTCGTGAGATGTTGGGTTAAG TCCCGCAACGAGCGCAACCCTCGTTCCATGTTGCCAGCACGTCGTGGTGGGGACTCATGGGAGACTGCCGGGGTCAACTCGGAGGAA GGTGAGGACGACGTCAAATCATCATGCCCCTTATGTCTTGGGCTTCACGCATGCTACAATGGCCGGTACAATGGGTTGCGATACTGT GAGGTGGAGCTAATCCCAAAAAGCCGGTCTCAGTTCGGATTGGGGTCTGCAACTCGACCCCATGAAGTCGGAGTCGCTAGTAATCGC AGATCAGCAACGCTGCGGTGAATACGTTCCCGGGCCTTGTACACACCGCC |
| Strain Morphology Photos | |
| Morphological Description | The morphology of Colony round;light-yellow;edge neatly;steamed bun shaped;slippy;sticky;The morphology of strain:spherical;no spore |